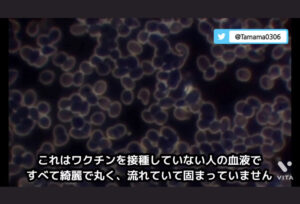
【ワクチン国内製造】モデルナ、日本にワクチン製造拠点の整備検討…BA・5対応は「11~12月に」

記事一覧


1: 時代を越える名無しザウルス 2013/06/02(日) 16:04:25.05 ID:zWfdtw4N パルクール・フリーランニングやってる奴集まろうず パルクール?なにそれ?って輩はこれを見ような http://ja.wikipedia.org/wiki/%E3%83%91%E3%83%AB%E3%82%AF%...

1: 時代を越える名無しザウルス 2022/09/26(月) 14:07:32.67 ID:4PDSaeL4d おかしくね? 引用元: 風呂45℃→熱くて死ぬサウナ90℃→ぬるい...
プロフィール
最近のコメント
表示できるコメントはありません。